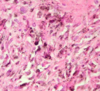

Há um constante balanço entre o ar ambiente e os mecanismos de defesa respiratórios que pode ser quebrado pelas características dos agentes inalados e do próprio hospedeiro (Verdadeiro / Falso)
Verdadeiro
Defina pneumoconiose.
O termo pneumoconiose refere-se às doenças causadas pela inalação de particulados sólidos e à consequente reação
tecidual do parênquima pulmonar
Doenças ocupacionais respiratórias agudas

Doenças ocupacionais respiratórias crônicas

Na gênese das doenças que afetam o parênquima pulmonar, o diâmetro aerodinâmico é fundamental, sendo que as partículas com menos de 10 μm, chamadas de __________, têm __________ (mais/menos) importância
“fração respirável”
mais
O que acontecem com as partículas maiores que 10 μm aspiradas?
ficam retidas na
região nasal
O que acontece com as partículas menores que 10 μm aspiradas?
Se depositam em qualquer nível
Dependendo do perfil da exposição e da solubilidade do gás, os
espaços aéreos distais podem ser acometidos, promovendo um
remodelamento do parênquima estrutural, causando:
Enfisema e fibrose.
Quanto à Resposta pulmonar frente a agentes inaláveis, o material particulado tende a predominar na área de __________ , poupando __________.
troca gasosa
vias aéreas de maior calibre
No caso das pneumoconioses, em situações de agressão continuada, pode haver prejuízo
funcional do transporte mucociliar, gerando __________ (mais / menos) retenção dos agentes tóxicos inalados.
mais
Em situações de agressão continuada, pode haver prejuízo
funcional do transporte mucociliar, gerando mais retenção dos
agentes tóxicos inalados.
Nestas situações, a limpeza das vias
passa a ser realizada predominantemente pela:
tosse
O maior tempo de permanências destas substâncias nos
brônquios e a permeação de substâncias irritantes através do fluido brônquico apresentam condições que favorecem processo inflamatório nas VVAA que pode se traduzir como:
- tosse produtiva,
- broncoconstricção,
- asma ocupacional
- Em algumas situações, a partícula tem a extrema capacidade de estimular a síntese do colágeno, como o asbesto, conseguindo uma deposição periférica acentuada, com fibrose pleural e peribronquiolar
A resposta pulmonar à inalação de poeiras inorgânicas
dependem de:
- natureza,
- dose,
- tempo de exposição,
- Podem ser modificadas pela presença de fatores imunológicos, presença de outros tipos de poeiras e pela existência de outras doenças
pulmonares
Diagnóstico em doenças ocupacionais respiratórias
História Ocupacional
Por que a história ocupacional é fundamental para o diagnóstico?
A história é fundamental para confirmar diagnóstico e etiologia do processo porque há uma inespecificidade das reações teciduais do trato respiratório aos agentes inalatórios ambientais e ocupacionais
Muitas vezes, o detalhamento do processo produtivo não pode ser dado pelo trabalhador por desconhecimento, o que fazer?
Nestes casos, o médico e sua equipe deve fazer uma pesquisa bibliográfica, além de conhecer o ambiente de trabalho específico do trabalhador, entrar em contato com técnicos e engenheiros de segurança, etc.
Todo passado ocupacional do paciente deve ser investigado, uma
vez que, para algumas doenças como câncer de pulmão, o que pode acontecer?
Haver um período de latência entre a doença e exposição,
Exemplo de compostos que podem se manifestar após um grande período de latência entre a doença e a exposição:
Compostos de arsênio, cromo hexavalente, formaldeído e asbesto
Por que no caso de Pneumoconioses, é importante saber a ocupação dos pais?
Importa também a ocupação dos pais, como nas exposições ao
asbesto, levado ao ambiente caseiro pelas roupas contaminadas
Por que informações sobre hobbies e atividades de lazer são importantes?
Informação sobre hobbies ou atividades de lazer também são
relevantes, como manipulação de resinas, epóxi, massas plásticas,
solda, madeiras alergênicas, etc.
(Existem / Não existem) __________ sintomas ou sinais clínicos específicos das pneumopatias ocupacionais.
Não existem
Pacientes com quadros
definidos de pneumoconioses podem ser assintomáticos?
Sim, inclusive com às vezes com alterações radiológicas exuberantes
Em toda inspiração no caso da asbestose, o que pode ser ouvido?
Podem ser ouvidos crepitantes nas bases pulmonares
Nas pneumoconioses, a principal ferramenta para vigilância epidemiológica é a:
Radiografia de tórax.